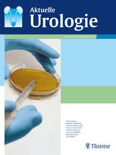

UROLOGIA INTERNATIONALIS
Scope & Guideline
Innovating Urology: Where Research Meets Practice
Introduction
Aims and Scopes
- Neuro-Urology:
Research related to the neurological aspects of urology, including the effects of neurological disorders on urinary function and the management of urological conditions in patients with neurological diseases. - Neurodegenerative Disorders:
Studies investigating the relationship between urological issues and neurodegenerative diseases like Parkinson's Disease and Alzheimer's Disease, exploring how these conditions impact urinary health. - Clinical Case Reports and Reviews:
Publication of detailed clinical case reports and comprehensive reviews that highlight novel findings and therapeutic approaches in urology, particularly those with neurological implications. - Innovative Treatment Strategies:
Exploration of new treatment methodologies, including pharmacological and non-pharmacological interventions, in managing urological conditions, especially in neurogenic bladder and related disorders. - Epidemiological Studies:
Research focusing on the prevalence and incidence of urological disorders in various populations, particularly in the context of neurological comorbidities.
Trending and Emerging
- Impact of COVID-19 on Neurological Health:
An emerging theme is the exploration of neurological complications related to COVID-19, with a focus on how these affect urological health, including urinary dysfunction post-infection. - Artificial Intelligence in Urology:
Increasing interest in the application of artificial intelligence and machine learning techniques in urology, particularly for diagnostics and treatment planning in patients with neurological disorders. - Interdisciplinary Approaches to Urological Disorders:
A growing trend towards interdisciplinary research that combines urology with neurology, geriatrics, and other fields to address complex patient needs and improve treatment outcomes. - Patient-Centered Care and Quality of Life:
Research focusing on patient-reported outcomes, quality of life assessments, and holistic treatment strategies for individuals with urological issues, particularly in the context of neurological conditions. - Innovative Rehabilitation Techniques:
Emerging studies on rehabilitation interventions, including physical therapy and neurorehabilitation strategies, aimed at improving urological function and overall patient quality of life.
Declining or Waning
- Traditional Urological Procedures:
There has been a noticeable decrease in studies centered on conventional urological surgical techniques, possibly due to advancements in minimally invasive and robotic-assisted surgeries overshadowing traditional methods. - Basic Urological Research:
Fewer papers are being published on purely basic research topics without a clinical or translational aspect, indicating a trend towards more applied research with immediate clinical relevance. - Pharmacological Studies on Common Urological Drugs:
Research focused on well-established pharmacological treatments for common urological conditions has waned, as the field shifts towards exploring novel therapeutic agents and treatment paradigms.
Similar Journals

UROLOGY
Fostering Collaboration in Urological AdvancementsUROLOGY is a prestigious journal published by Elsevier Science Inc, renowned for disseminating high-quality research and reviews in the field of urology. With an ISSN of 0090-4295 and E-ISSN 1527-9995, this journal has been a trusted resource since its inception in 1973 and continues to provide insights into the latest advancements and clinical practices in urology, maintaining a category quartile of Q2 as of 2023. The journal ranks 50th out of 120 in the Scopus metrics for Medicine - Urology, placing it in the 58th percentile, which underscores its influence and relevance in the academic community. Although it is not structured as an open access journal, it offers a wealth of knowledge vital for researchers, healthcare professionals, and students alike, enabling them to stay abreast of evolving treatments and innovations in the field. As we move towards 2024, UROLOGY remains committed to advancing research and enhancing practices in urological care, fostering a collaborative environment among its readership.

Research and Reports in Urology
Advancing urological science through groundbreaking research.Research and Reports in Urology, published by DOVE MEDICAL PRESS LTD, is a premier journal dedicated to the dissemination of cutting-edge research and clinical advancements in the field of urology. With an impressive impact factor and a recognized status as Q2 within the urology category, this journal offers a vital platform for researchers, practitioners, and students eager to engage with the latest findings and methodologies. Since its inception in 2009, the journal has embraced an Open Access model, ensuring that critical research is freely available to the global community, thereby fostering collaboration and innovation in urological science. Based in New Zealand, it operates within a robust international framework, allowing for a diverse range of contributions that address pressing issues in urology and enhance professional knowledge. Researchers are encouraged to submit their work and become part of this influential discourse, as the journal continues to navigate the rapidly evolving landscape of urological health from 2012 to 2024 and beyond.

Urology Case Reports
Fostering global collaboration in urological case reporting.Urology Case Reports is a premier open access journal dedicated to the rapid dissemination of clinical case studies in the field of urology. Published by Elsevier Science Inc, this journal has been providing valuable insights and advancements in urological science since its inception in 2013. With a focus on unique and impactful case reports, it serves as an essential resource for researchers, healthcare professionals, and students seeking to stay at the forefront of urological medicine. Operating from its headquarters in New York, NY, the journal has established itself within the medical community, currently holding a Category Quartile ranking of Q3 in Urology as per the 2023 metrics, and is positioned at the 29th percentile within its Scopus rank for the Medicine - Urology category. The open access model promotes broad accessibility, allowing for a global exchange of knowledge, which is critical for advancing clinical practices. By bridging clinical findings and practical applications, Urology Case Reports plays a pivotal role in enhancing urological care and education.

Nature Reviews Urology
Transforming urological care through scholarly excellence.Nature Reviews Urology, published by NATURE PORTFOLIO, stands as a leading journal in the field of urology, showcasing cutting-edge research and reviews that address the complexities and advancements within this dynamic medical specialty. With a 2023 impact factor that places it firmly in the Q1 quartile of urology journals, it ranks impressively within the top 3 out of 120 in Scopus, highlighting its critical role in disseminating significant academic findings. As a premier source of scholarly information, this journal aims to provide urology professionals, researchers, and students with comprehensive insights into the latest clinical practices, therapeutic developments, and technological innovations, promoting a deeper understanding of urological conditions. The journal also ensures accessibility to its articles, demonstrating a commitment to the open dissemination of knowledge essential for advancing urology research and practice.

Journal of Pediatric Urology
Fostering collaboration to enhance pediatric urological care.Journal of Pediatric Urology is a leading academic journal dedicated to the intersection of pediatric medicine and urological science. Published by ELSEVIER SCI LTD, this esteemed journal provides a vital platform for the dissemination of innovative research and clinical advancements in the field. With a 2023 impact factor that places it within the Q2 quartile for Pediatrics, Perinatology and Child Health, and the Q1 quartile for Urology, it is recognized among the top-tier journals in both domains. The journal covers a broad spectrum of topics from minimally invasive surgical techniques to management strategies for congenital urological disorders. This makes it an invaluable resource for researchers, clinicians, and students who seek to improve pediatric urological care. As the journal continues to evolve, it aims to foster interdisciplinary collaboration that drives further advancements in pediatric health. For those looking to avoid publication barriers, the journal retains traditional access options while contributing to the global growth of pediatric urology research from its base in the Netherlands.

INTERNATIONAL JOURNAL OF UROLOGY
Connecting professionals through essential urological insights.INTERNATIONAL JOURNAL OF UROLOGY is a leading peer-reviewed publication in the field of urology, launched in 1994 and published by Wiley. As an essential resource for researchers, clinicians, and students alike, the journal holds a distinguished position in the academic landscape, evidenced by its Q2 ranking in Urology and its impressive Scopus rank of 29 out of 120, placing it in the 76th percentile of its field. The journal aims to disseminate high-quality research and advancements in urological science, covering a broad spectrum of topics including clinical practices, innovative treatments, and emerging technologies. With a commitment to fostering knowledge and advancement in medicine, INTERNATIONAL JOURNAL OF UROLOGY serves as a vital platform for dialogue and discovery among professionals dedicated to improving patient care in urology. Although it does not offer open access, its comprehensive articles and insights are crucial for anyone engaged in urological research and practice.

Urological Science
Leading the Charge in Urological Research and EducationUrological Science, published by Lippincott Williams & Wilkins, is a prominent open-access journal that has been a vital resource for the Urology field since its establishment in 2010. With a focus on innovative research and advancements in urological science, the journal aims to disseminate significant findings and encourage dialogue among physicians, researchers, and healthcare professionals worldwide. The journal has achieved a commendable Q3 rank within its category according to the latest quartiles released in 2023 and holds a Scopus rank of #80 out of 120 in the Medicine Urology field, placing it in the 33rd percentile. By providing an open-access platform, Urological Science ensures that vital research is easily accessible to a global audience, supporting the ongoing advancements in urological healthcare and education. As the landscape of urology evolves, this journal remains an essential vehicle for sharing knowledge and improving patient outcomes, making it an invaluable resource for anyone invested in the future of urological science.

African Journal of Urology
Leading the Charge in Urological ResearchAfrican Journal of Urology (ISSN: 1110-5704, E-ISSN: 1961-9987) is a leading scholarly publication in the field of urology, published by SPRINGER from the United Kingdom. Since adopting an open access model in 2012, this journal has aimed to increase the visibility and dissemination of vital research findings across the African continent and beyond. With a current impact factor and significant standing, as denoted by its Q3 ranking in Urology for 2023, it serves as an essential platform for clinicians, researchers, and students alike. The journal's scope encapsulates all aspects of urology, fostering advancements in both clinical practices and innovative research while specifically addressing healthcare challenges relevant to African populations. As part of its commitment to accessibility and academic excellence, the journal offers full open access to its content, allowing for a broad readership and engagement with cutting-edge studies. Engage with the African Journal of Urology to contribute to and stay informed about vital developments in urological science.

INTERNATIONAL UROLOGY AND NEPHROLOGY
Driving Clinical Excellence in Urology and NephrologyINTERNATIONAL UROLOGY AND NEPHROLOGY, published by SPRINGER, stands as a premier journal in the fields of urology and nephrology, boasting a commendable impact factor as reflected in its Q2 category rankings in both domains as of 2023. Since its inception in 1970, the journal has dedicated itself to disseminating cutting-edge research and clinical advancements that significantly impact the practice and understanding of urology and nephrology. With a Scopus rank placing it in the upper percentiles—46th out of 120 in urology and 38th out of 81 in nephrology—it offers a vital platform for researchers, healthcare professionals, and students alike to engage with high-quality, peer-reviewed articles. Although it does not operate as an open access journal, the wealth of knowledge contained within its pages remains indispensable for those committed to advancing the medical fields of urology and nephrology. The journal is located in Dordrecht, Netherlands, emphasizing its commitment to global research collaboration.
American Journal of Clinical and Experimental Urology
Bridging the gap between research and clinical application in urology.American Journal of Clinical and Experimental Urology is a pivotal platform for the dissemination of cutting-edge research in the field of urology. Published by E-CENTURY PUBLISHING CORP, this peer-reviewed journal aims to enhance the understanding and application of clinical and experimental practices in urological science. The journal prioritizes high-quality, original research articles, reviews, and case studies that provide valuable insights for urologists, researchers, and healthcare professionals alike. With an increasing focus on evidence-based approaches to urological health, AJCEU serves as an essential resource for those who strive to advance diagnostic and therapeutic methodologies. Though currently not indexed in major databases, the journal is committed to expanding its reach within the academic community, thus fostering collaboration and innovation in urology. The open access model allows for broader distribution and engagement with the latest findings in the field, making it an indispensable tool for scholars and practitioners dedicated to advancing urological care and research.